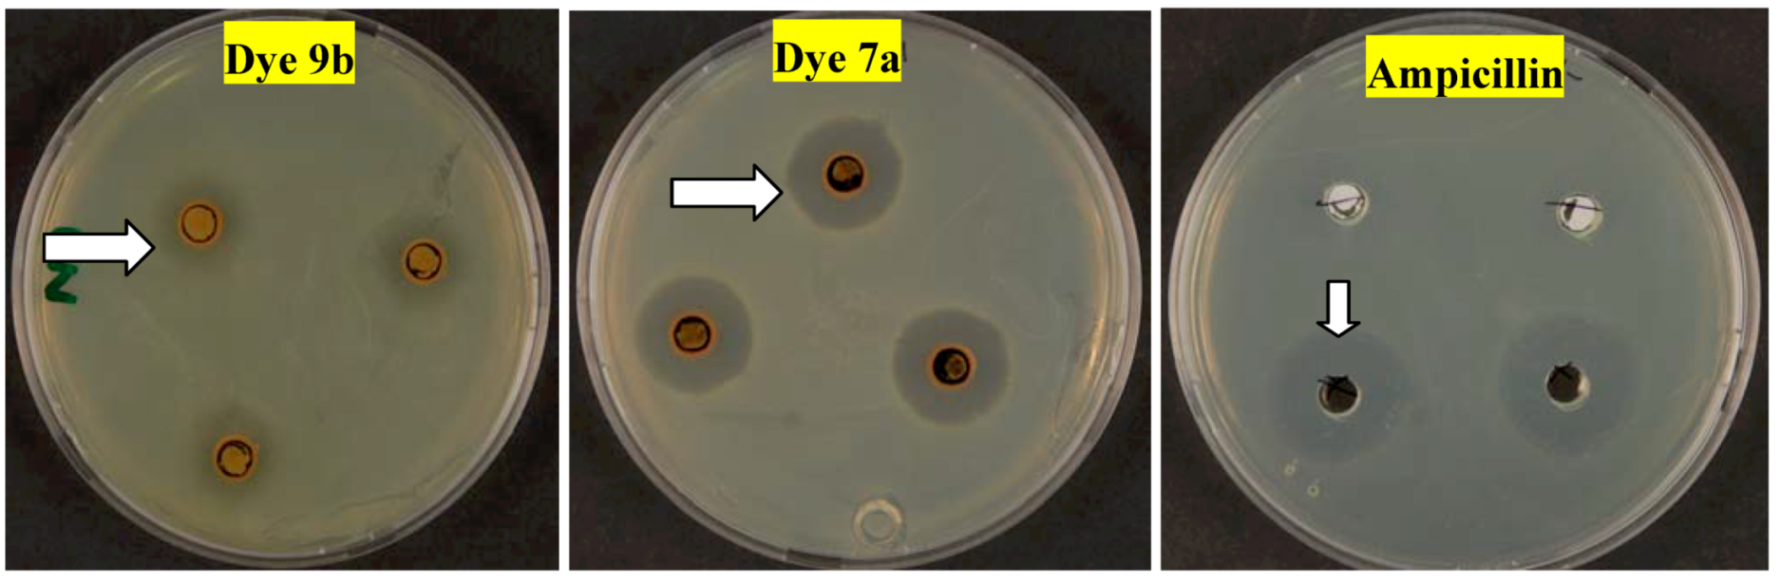
Molecules 17 11495 g002 550

A Facile Synthesis of Arylazonicotinates for Dyeing Polyester Fabrics under Microwave Irradiation and Their Biological Activity Profiles
Abstract
:1. Introduction
2. Results and Discussion
2.1. Synthesis



2.2. Dyeing
| Dye No. | UV, [ λmax (DMF)/nm] | Molar extinction coefficient (mol−1 cm −1) | K/S | L * | A * | B * | C * | H |
|---|---|---|---|---|---|---|---|---|
| 7a | 371 | 16,484 | 19.30 | 51.58 | 14.63 | 39.13 | 41.78 | 69.50 |
| 7b | 368 | 9,237 | 20.48 | 34.08 | 0.87 | 12.74 | 12.77 | 86.11 |
| 7c | 349 | 6,813 | 17.10 | 40.76 | 9.15 | 25.31 | 26.92 | 70.13 |
| 7d | 347 | 11,762 | 16.89 | 58.82 | 8.74 | 36.37 | 37.41 | 76.49 |
| 7e | 360 | 10,769 | 10.27 | 50.60 | 4.65 | 22.63 | 23.10 | 78.40 |
| 9a | 374 | 16,524 | 22.02 | 54.95 | 18.01 | 48.60 | 51.83 | 69.67 |
| 9b | 373 | 9,499 | 21.22 | 52.53 | 13.85 | 41.29 | 43.56 | 71.44 |
| 9c | 379 | 25,924 | 25.50 | 56.06 | 21.78 | 57.05 | 61.07 | 69.10 |
| Dye No. | Color shade on polyester | Wash fastness | Perspiration fastness | Light fastness | |||||||
|---|---|---|---|---|---|---|---|---|---|---|---|
| Alkaline | Acidic | ||||||||||
| Alt | SC | SW | Alt | SC | SW | Alt | SC | SW | |||
| 7a | Yellow | 5 | 5 | 5 | 5 | 5 | 5 | 5 | 4–5 | 5 | 2–3 |
| 7b | Brownish-green | 5 | 5 | 5 | 5 | 5 | 5 | 5 | 4–5 | 5 | 2–3 |
| 7c | Yellowish-brown | 4–5 | 4–5 | 4–5 | 5 | 5 | 5 | 5 | 4–5 | 5 | 2–3 |
| 7d | Yellow | 5 | 4–5 | 5 | 5 | 5 | 5 | 5 | 4–5 | 5 | 4–5 |
| 7e | Yellowish-brown | 5 | 5 | 5 | 5 | 5 | 5 | 5 | 4–5 | 5 | 3–4 |
| 9a | Dark yellow | 5 | 4–5 | 5 | 5 | 5 | 5 | 5 | 4–5 | 5 | 2–3 |
| 9b | Yellowish-brown | 5 | 5 | 5 | 5 | 5 | 5 | 5 | 4–5 | 5 | 4–5 |
| 9c | Yellowish-orange | 5 | 5 | 5 | 5 | 5 | 5 | 5 | 4–5 | 5 | 3–4 |
2.3. Antimicrobial Activities
| Compound No | Inhibition zone diameter (Nearest mm) | ||||
|---|---|---|---|---|---|
| B. subtilis Mean ± SD | S. aureus Mean ± SD | E. coli Mean ± SD | P. aeruginosa Mean ± SD | C. albicans Mean ± SD | |
| 7a | 0.1 ± 0.08 | 15 ± 0.02 | 7 ± 0 | - | - |
| 7b | - | 11 ± 0.87 | - | - | - |
| 7c | 0.7 ± 0.13 | 16 ± 0 | - | - | 7 ± 0.07 |
| 7d | 0.1 ± 0 | 16 ± 0.08 | - | - | 12 ± 0.1 |
| 9a | - | 13 ± 0 | 7 ± 0 | 7 ± 0.05 | - |
| 9b | - | 10 ± 0.2 | - | - | - |
| Ampicillin * | 30 ± 0.05 | 46 ± 0.7 | 31 ± 0.14 | 17 ± 0.07 | |
| Cyloheximide ** | - | ||||
3. Experimental
3.1. General
3.2. High Temperature Dyeing Method (HT)
3.2.1. Materials
3.2.2. Dyeing
3.3. Color Measurements and Analyses
3.3.1. Color Measurements

3.3.2. Fastness Testing
3.4. Antimicrobial Activities Test
4. Conclusions
Acknowledgments
- Sample Availability: Samples of compounds 2d, 7a–e and 9–c are available from the authors.
References
- Annen, O.; Egli, R.; Hasler, R.; Henzi, B.; Jakob, H.; Matzinger, P. Replacement of disperseanthraquinone dyes. Color. Technol. 1987, 17, 72–85. [Google Scholar]
- Dawson, J.F. Developments in disperse dyes. Color. Technol. 1978, 9, 25–35. [Google Scholar] [CrossRef]
- Malik, G.M.; Zadafiya, S.K. Thaizole based disperse dyes and their dyeing application on polyester fiber and their antimicrobial activity. Chem. Sin. 2010, 1, 15–21. [Google Scholar]
- Khan, M.K.; Abdul, M.J.; Shahnaz, P.; Rasheeda, P.; Moazzam, H.S. Synthesis of ethyl-4,6-dihydroxy-2-oxo-1-phenyl-5-arylazopyridine-3-carboxylate, part (IV): New disperse dyes. J. Chem. Soc. Pak. 2010, 32, 505–510. [Google Scholar]
- El-Kashouti, M.A.; El Molla, M.M.; Elsayad, H.S.; Ahmed, K.A.; Helal, M.H.; Elgemeie, G.H. Synthesis of several new pyridine-2(1H) thiones containing an arylazo function and their applications in textile printing. Pigm. Resin Technol. 2008, 37, 80–86. [Google Scholar] [CrossRef]
- Parveen, R.; Ahmed, M.A.; Husain, S.A.; Parveen, S. New disperse dyes from substituted pyridines. Part-I: Synthesis of methyl 4,6-dihydroxy-2-oxo-1-phenyl-5-arylazopyridine-3-carboxylate and their derivatives. J. Sci. Ind. Res. 2001, 44, 244–247. [Google Scholar]
- Rasheeda, P.; Shahnaz, P.; Ausaf, A.; Khan, K.M. 1H-NMR, mass spectroscopic studies and color fastness properties of methyl-4,6-dihydroxy-2-oxo-1-phenyl-5-arylazopyridine-3-carboxylate, part III: new disperse dyes. Nat. Prod. Res. 2007, 21, 7–12. [Google Scholar] [CrossRef]
- Lin, J.-G; Qiu, L.; Cheng, W.; Luo, S.-N.; Wang, K.; Meng, Q.-J. A novel cobalt (II) complex based on nicotinamide and 2-nitrobenzoate mixed ligands: Synthesis, characterization, and biological activity. Inorg. Chem. Commun. 2010, 13, 855–858. [Google Scholar] [CrossRef]
- Al-Mousawi, S.M.; El-Apasery, M.A.; Mahmoud, H.; Elnagdi, M.H. Studies Biologically Active Enaminones: An Easy Method for Structural Elucidation of Products Produced from Enaminone Starting Materials through Pathways Employing Microwave Irradiation. Int. Res. J.Pure Appl. Chem. 2012, 2, 77–90. [Google Scholar]
- El-Apasery, M.A.; Al-Mousawi, S.M.; Mahmoud, H.; Elnagdi, M.H. Novel Routes to Biologically Active Enaminones, Dienoic Acid Amides, Arylazonicotinates and Dihydropyridazines under Microwave Irradiation. Int. Res. J. Pure Appl. Chem. 2011, 1, 69–93. [Google Scholar]
- Kim, K-R; Rhee, S-D; Kim, H. Y.; Jung, W. H.; Yang, S-D; Kim, S. S.; Ahn, J. H.; Cheon, H. KR-62436, 6-{2-[2-(5-cyano-4,5-dihydropyrazol-1-yl)-2-oxoethylamino]ethylamino}nicotinonitrile, is a novel dipeptidyl peptidase-IV (DPP-IV) inhibitor with anti-hyperglycemic activity. Eur. J. Pharm. 2005, 518, 63–70. [Google Scholar] [CrossRef]
- Mohanta, G.P.; Manna, P.K.; Manavalan, R. Physicochemical and biological evaluation of erythromycin nicotinate, a new derivative of erythromycin. Indian J. Pharm. Sci. 2002, 64, 489–491. [Google Scholar]
- Al-Mousawi, S.M.; El-Apasery, M.A. Condensation reactions of 3-oxo-2-arylhydrazono-propanals with active methylene reagents: Formation of 2-hydroxy- and 2-amino-6-substituted-5-arylazonicotinates and pyrido[3,2-c]cinnolines via 6π-electrocyclization reactions. Molecules 2012, 17, 6547–6556. [Google Scholar] [CrossRef]
- Courtot, P.; Pichon, R.; le Saint, J. Syn-anti-Photoisomerisation of chelated arylhydrazones of 1,2,3-triketones: A correction. J. Chem. Soc. Perkin Trans. 2 1981, 1981, 219–219. [Google Scholar]
- CCDC 854845 contain the supplementary crystallographic data for compound 2d in this paper. This data can be obtained free of charge from the Cambridge Crystallographic Data Centre via http://www.ccdc.cam.ac.uk.
- Hassaneen, H.M.E.; Abdallah, T.A.; Hassaneen, H.M.; Elnagdi, M.H. Functionally Substituted Enamines As Building Blocks in Heterocyclic Synthesis: Reactivity of Glyoxaldiphenylhydrazone Toward Electrophilic Reagents. J. Chem. Res. 2005, 11, 729–732. [Google Scholar]
- Chrysler, L.P. Methods of Test for Color Fastness of Textiles and Leather, 7th ed; Bradford: London, UK, 1990; pp. 89–94. [Google Scholar]
- Isaacson, D.M.; Kirschbaum, J. Assays of antimicrobial substances. In Manual of Industrial Microbiology and Biotechnology; Demain, A.L., Solomon, N.A., Eds.; ASM Press: Washington, DC, USA, 1986; pp. 410–435. [Google Scholar]
© 2012 by the authors; licensee MDPI, Basel, Switzerland. This article is an open-access article distributed under the terms and conditions of the Creative Commons Attribution license (http://creativecommons.org/licenses/by/3.0/).
Share and Cite
Al-Mousawi, S.M.; El-Apasery, M.A.; Mahmoud, H.M. A Facile Synthesis of Arylazonicotinates for Dyeing Polyester Fabrics under Microwave Irradiation and Their Biological Activity Profiles. Molecules 2012, 17, 11495-11506. https://doi.org/10.3390/molecules171011495
Al-Mousawi SM, El-Apasery MA, Mahmoud HM. A Facile Synthesis of Arylazonicotinates for Dyeing Polyester Fabrics under Microwave Irradiation and Their Biological Activity Profiles. Molecules. 2012; 17(10):11495-11506. https://doi.org/10.3390/molecules171011495
Chicago/Turabian StyleAl-Mousawi, Saleh M., Morsy A. El-Apasery, and Huda M. Mahmoud. 2012. "A Facile Synthesis of Arylazonicotinates for Dyeing Polyester Fabrics under Microwave Irradiation and Their Biological Activity Profiles" Molecules 17, no. 10: 11495-11506. https://doi.org/10.3390/molecules171011495
APA StyleAl-Mousawi, S. M., El-Apasery, M. A., & Mahmoud, H. M. (2012). A Facile Synthesis of Arylazonicotinates for Dyeing Polyester Fabrics under Microwave Irradiation and Their Biological Activity Profiles. Molecules, 17(10), 11495-11506. https://doi.org/10.3390/molecules171011495
